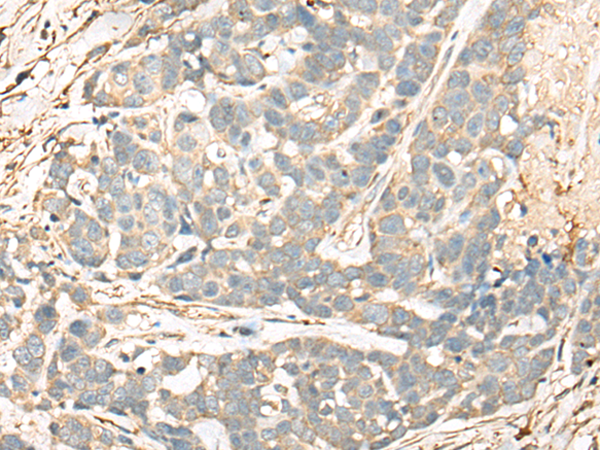

中文名稱:兔抗CD55多克隆抗體
英文名稱: Anti-CD55 rabbit polyclonal antibody
別 名: CR; TC; DAF; CROM
相關(guān)類別: 一抗
儲 存: 冷凍(-20℃)
宿 主: Rabbit
抗 原: CD55
反應(yīng)種屬: Human
標(biāo) 記 物: Unconjugate
克隆類型: rabbit polyclonal
技術(shù)規(guī)格
|
Background: |
This gene encodes a glycoprotein involved in the regulation of the complement cascade. Binding of the encoded protein to complement proteins accelerates their decay, thereby disrupting the cascade and preventing damage to host cells. Antigens present on this protein constitute the Cromer blood group system (CROM). Alternative splicing results in multiple transcript variants. The predominant transcript variant encodes a membrane-bound protein, but alternatively spliced transcripts may produce soluble proteins. |
|
Applications: |
ELISA, WB, IHC |
|
Name of antibody: |
CD55 |
|
Immunogen: |
Fusion protein of human CD55 |
|
Full name: |
CD55 molecule, decay accelerating factor for complement (Cromer blood group) |
|
Synonyms: |
CR; TC; DAF; CROM |
|
SwissProt: |
P08174 |
|
ELISA Recommended dilution: |
5000-10000 |
|
IHC positive control: |
Human ovarian cancer and human thyroid cancer |
|
IHC Recommend dilution: |
25-100 |
|
WB Predicted band size: |
41 kDa |
|
WB Positive control: |
PC-3 and K562 cell lysates |
|
WB Recommended dilution: |
500-2000 |

購物車
幫助
021-54845833/15800441009
